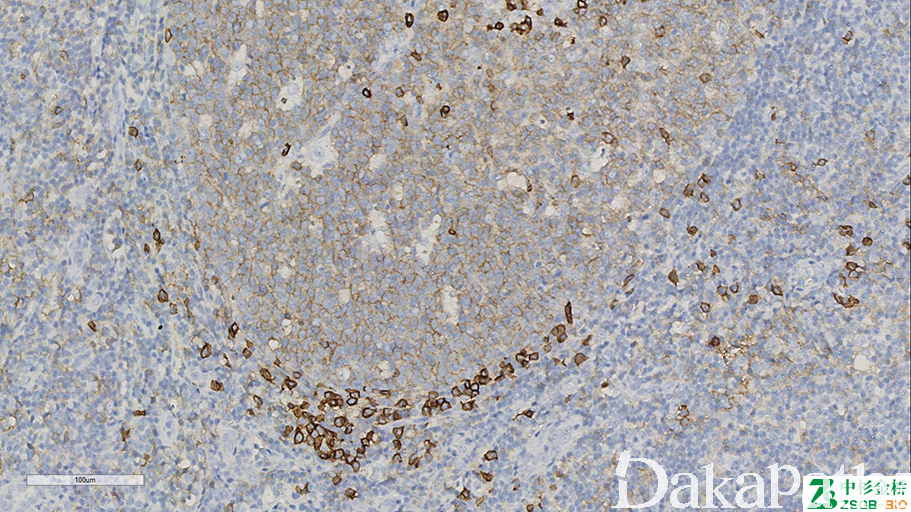

CD38

别名: ADP-ribosyl cyclase 1
概述:
分子量 46KD 的穿膜糖蛋白,浆细胞强表达,活化的 T、 B 细胞及 NK 细胞亦有表达。
信号定位: 胞膜
在病理学中的应用:
浆细胞肿瘤的诊断。
- Identify plasma cells and plasmablastic differentiation
- Diagnosis of myeloma
- Prognosis for CLL patients (presence on 30% or more B-CLL cells by flow cytometry is associated with poor prognosis (Leukemia 2005;19:750)
- May be due to direct signaling role in these cells (Blood 2003;102:2146)
商品化试剂(排名不分先后,本网站对抗体质量不负责!)
公司 | 克隆号 | 即用型(ml) | 原液(ml) | ||||
赛诺特 | SPC32 | 1 | 3 | 6 | / | 0.1 | 0.2 |
SP149 | 1 | 3 | 6 | / | 0.1 | 0.2 | |
基因科技 | 38C03 | 1 | 2 | 4 | 7 | / | 0.2 |
中杉金桥 | SPC32 | 1.5 | 3 | 6 | / | 0.1 | 0.2 |
安必平 | SP149 | 1.5 | 3 | 6 | / | 0.1 | 0.2 |
福建迈新 | 38C03 | 1.5 | 3 | 6 | / | / | 0.2 |
在肿瘤中的表达情况:
几乎全部阳性(≥95%的病例阳性): 弥漫大 B 细胞淋巴瘤,c-myc 重排、浆细胞骨髓瘤,浆母细胞性
通常阳性(<95%,≥75%的病例阳性): Burkitt 淋巴瘤
经常阳性(<75%,≥55%的病例阳性): 原发性渗出性淋巴瘤,HHV-8 相关、浆母细胞性淋巴瘤
有时阳性(<55%,≥35%的病例阳性): 脾脏边缘区淋巴瘤、边缘区 B 细胞淋巴瘤
偶尔阳性(<15%,≥5%的病例阳性): 弥漫大 B 型大 B 细胞淋巴瘤,非特指型、经典型霍奇金淋巴瘤、结节性淋巴细胞为主型霍奇金淋巴瘤
几乎全部阴性(<5%的病例阳性): 淋巴细胞丰富型经典型霍奇金淋巴瘤
